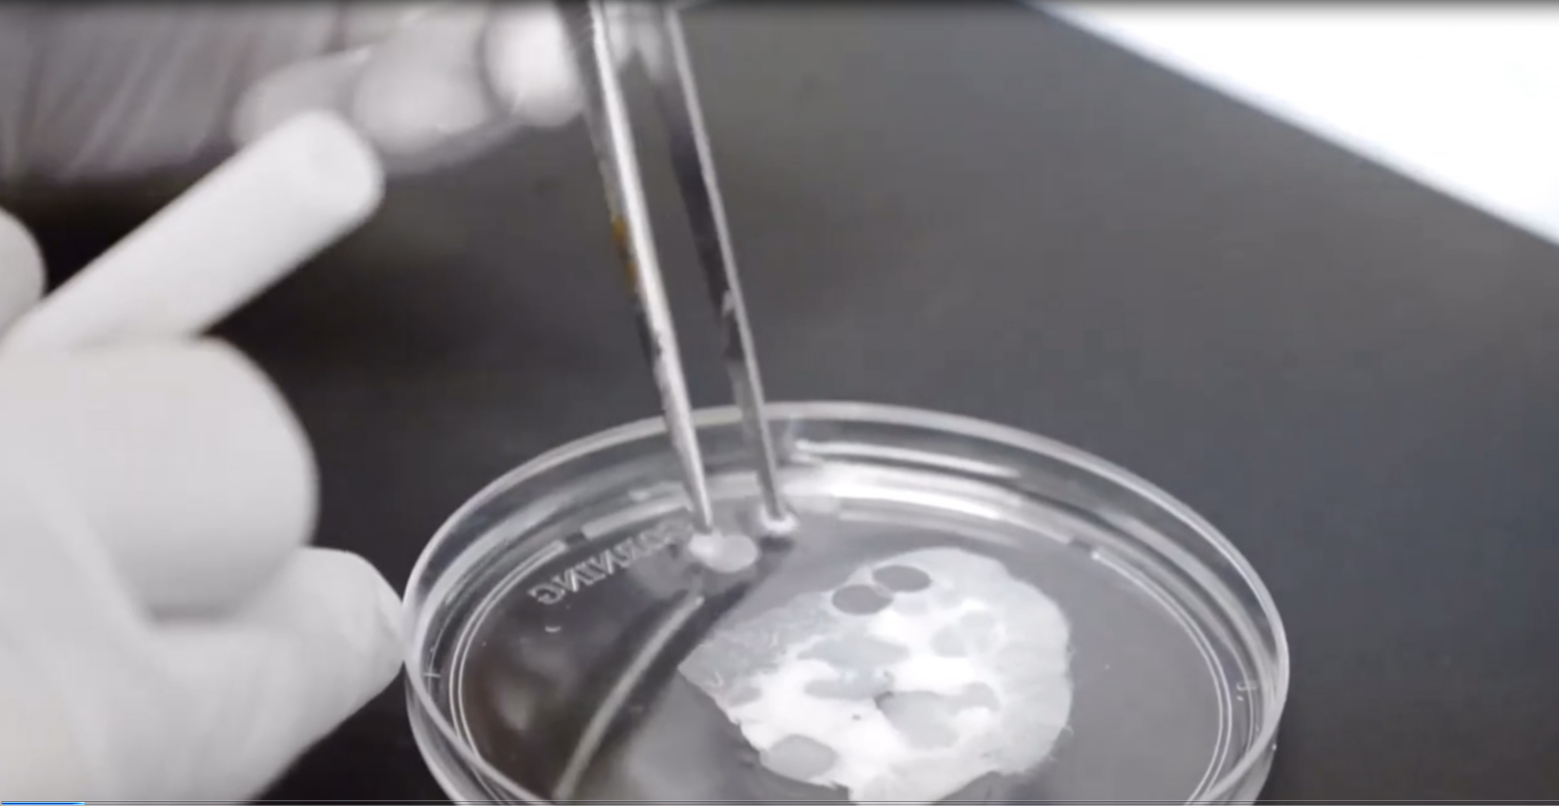

A deep dive into the clinical evidence behind Sweet Chemistry®

Science Belongs in a Lab
At the heart of our skincare formulations is the cutting edge science of our parent company Xylyx Bio, a biotechnology company made up of an interdisciplinary team of biomedical engineers, surgeons, physicians, and scientists working to save lives through bioengineering and based in the SUNY Downstate Advanced Biotechnology Incubator in Brookyn, New York.

Inventing Matrikine Biotechnology for Organ Repair
Xylyx Bio develops extracellular matrix biomaterials for the study of surgical lung sealants and to advance drug discovery in cancer and fibrosis.
These biomaterials, called Matrikynes®, also have remarkable benefits in skin tissue regeneration.
Matrikynes® matrix-derived polypeptides have been developed in our 2,200 sq. ft. NIH-funded research lab and are manufactured utilizing a complex proprietary process in our ISO 9001-compliant production facility - all housed within the SUNY Downstate Medical Center in New York.

Saving Lives Through Bioengineering Donor Organs for Transplant
The wait for an organ transplant is a battle against time. Many patients spend years on the transplant waiting list, only to face rejection, complications, or even death while waiting for an organ to become available.
Xylyx Bio transforms discarded otherwise unutilized donor organs into fullly functional, anatomically compatible bioengineered whole organ grafts for life-saving transplantation.

Build Collagen Without The Trauma
Sweet Chemistry Products
Our products repair your skin and visibly restore dermal collagen in only 4 weeks without causing damage by forming healthy, living tissue.
> This improves your skin quality as you age and allows you to stave off invasive procedures a little longer.
Current Practices
Most cosmetic treatments that promise to “build collagen” (ablative lasers, radiofrequency microneedling, bio-stimulatory injectables, etc.) have the potential to damage your skin by forming non-functioning scar tissue.
> According to a survey by The Aesthetic Society, plastic surgeons are reporting that many of these treatments can decrease skin quality/function over time and make it more difficult to perform future invasive procedures.

Upgrade to Hundreds of Bioactive Polypeptides
Sweet Chemistry Products
Sweet Chemistry formulas contain 3% Matrikynes® polypeptides.
> These proprietary polypeptides that consists of over 300 natural extracellular matrix polypeptides are highly bioavailable and clinically proven to enhance the structure, function, and appearance of skin.
> Matrikynes® are also currently used in some of the most advanced areas of biomedical research, specifically in clinical applications for organ tissue repair.
Current Practices
Chemically-synthesized, artificial peptides traditionally used in cosmetic formulas are singular and thought to provide limited regenerative benefits to your skin, making them less bioavailable.

Less Marketing, More Space for Actives
Sweet Chemistry Products
We use a modern, transparent approach to formulating: All of our dermatological active ingredients are included at functional levels, with our botanical actives at a minimum of 1% each. In our ingredient list, we’re also always transparent about our 1% line.
> For our Elasticity Reinforcing Cream, this means we formulate using 30% less water with antioxidants and actives making up 45% of our emulsion.
> For our Reparative Oil Serum Infusion, it means you’re getting a waterless serum formulated with powerful dermatological actives at functional levels, and efficacious conventional pesticide-free botanicals each at a minimum of 6%.
Current Practices
Many dermatological and botanical actives you will find in conventional cosmetic products are formulated at marketing levels, sometimes referred to as “ingredient stories”.
> This means your favorite product may only contain around 0.01% of any given active ingredient. This percentage is all it takes for an ingredient to appear in the ingredients list and be marketed to you as a “hero” ingredient. (The above percentage does not refer to prescription strength actives such as all-trans retinoic acid aka tretinoin.)

Botanicals & Preservatives That Keep Your Microbiome in Mind
Sweet Chemistry Products
Our botanical oils and extracts are not only certified organic and free from the most harmful pesticides but smartly protected and preserved without the need for excessive preservatives.
> This gives you the convenience of shelf-life (6 month period after opening) without compromising your microbiome or putting farmers’ health at risk.
Current Practices
Most traditional formulas use botanical ingredients that contain pesticide residues and are preserved with the goal of maximizing shelf-life (average period after opening date: 12 months).
> While preservatives are essential in extending shelf-life and ensuring the safety of water-based products, they’re often used in excess.
> Pesticides can deplete your skin’s microbiome over time, harm farmers, animals, and other organisms, and even contribute to global warming.

The World’s First Airless Glass Packaging
Sweet Chemistry Products
Meet the world’s first glass airless bottle: Aside from the small plastic overcap, our packaging is crafted from Italian glass that is ultra-light in weight, so light in fact, some of our customers have even mistaken it for plastic.
> Using 87% less plastic by mass than plastic airless and glass dropper bottles, our packaging helps us control our carbon emissions.
> We also designed our bottle so you are able to dispense every last drop of product and opted for a narrow opening to keep the formula more stable than average airless or dropper bottles.
Traditional Packaging
Most airless bottles used for skincare are made from plastic. While the beauty industry is making an effort to use alternative materials such as glass, most glass used for beauty products tends to be heavier in weight than plastic packaging and therefore not the more eco-friendly choice.
> At the same time, relying too much on plastic packaging is damaging to our environment, oceans, and habitats.
Clinicals
Independent clinical studies show that Matrikynes® deliver statistically significant improvements for multiple skin types and tones: In a clinical study of 56 women of varying race and ethnicities, Matrikynes® showed statistically significant improvements in skin barrier function, skin barrier repair, skin density, skin hydration, hyperpigmentation, and global fine lines and wrinkles.

Bioengineering Is at the Heart, Lungs & Skin of What We Do
Aside from being our award-winning formulas’ defining ingredient, Matrikynes® are used in clinical applications in regenerative medicine: They were born from the innovative research in tissue repair technologies by Dr. John O’Neill (originally from Columbia University's Laboratory for Stem Cells and Tissue Engineering) and his team at our parent company Xylyx Bio.
Beyond creating this novel peptide technology we use in our products exclusively, Xylyx Bio develops biomaterials and organ support systems: From lifesaving surgical lung sealants, to advanced platform technologies for organ rehabilitation and transplantation, to helping discover novel cancer and fibrosis treatments.

8 Years of Research & over $8 Million In NIH Government Funding
Originally used in clinical applications to repair lung tissue, Matrikynes® are a proprietary combination of potent bioactive matrikine signal peptides. Matrikine signal peptides have been shown to improve the structure, function, and appearance of skin.
• Increased Cellular Renewal By 336%
• Reduced Wound Size By 421%
• Increased Regenerative Gene Expression By 316%
The Origins of Matrikynes®
These matrikine signal peptides are derived from extracellular matrix (ECM), the essential, life-sustaining substance that surrounds every cell in your body. Without extracellular matrix, life could not exist.
ECM gives cells the ability to organize and communicate which signals your skin to regenerate and repair.

Finding Healing in the Extracellular Matrix
Skin tissue is made up of water, cells, and an essential substance called extracellular matrix (ECM). The ECM is made up of structural proteins you might be familiar with such as collagen, elastin, laminin, and fibronectin, and contain components such as hyaluronic acid, ceramides, squalene, glycosaminoglycans, cholesterol, minerals, epidermal growth factors, and many other substances that are essential to the human body.
Skin ECM supports cell function and helps cells communicate, repair, and regenerate, which is essential for maintaining a healthy skin barrier. Over time, due to factors like sun exposure, stress, and aging, skin ECM starts to break down, resulting in a progressive loss of important ECM components like collagen, which eventually leads to the development of fine lines and wrinkles.
While traditional formulas use synthetic/artificial peptides to help rebuild collagen with some success, we also formulate with our proprietary, highly bioavailable matrix-derived polypeptides, which are derived from ethically-sourced, USDA-compliant, upcycled bovine bones the food industry would otherwise discard.
What makes bone the source of choice for our polypeptides is that it is a tissue with natural regenerative properties and an unparalleled reparative capacity.

Unlocking Unparalleled Skin Health
To create Sweet Chemistry Matrikynes®, our scientists break down extracellular matrix proteins into skin penetrable peptide fragments using a process known as proteolysis.
As one of the defining actives in our products, these proprietary Matrikynes®polypeptides act as a signal that tells your skin to produce more collagen which helps reduce the appearance of fine lines/wrinkles. Matrikynes® also help maintain and improve overall skin texture, and firmness, as well as target redness, hyperpigmentation, and skin barrier concerns.
Explore the Research That Inspires Our Products:
Learn how experts in tissue regeneration at our parent company Xylyx Bio are advancing regenerative medicine utilizing extracellular matrix platforms
Shop Sweet Chemistry
Formulated to be used individually or mixed together for customizable emollience, hydration, and activity.



